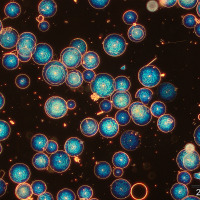

IOW Photo contest 2017
Marine research in all its beauty
Again and again the people at IOW manage to capture their work and impressions around it in very expressive and aesthetic pictures. This was demonstrated very nicely by the institute’s second photo contest: 18 contributors submitted a total of 120 photos, which were taken in various work contexts.
This time, the appointed jury was the IOW community, who had the opportunity to vote for three favorite photos in each of the three categories. The result therefore not only highlights the photographic skills of the IOW people but also reflects, which topics are especially close to their hearts. We are proud to present the winning photos in the categories „People, Work, Emotions“, „Colours, Patterns, Structures“ and „Measuring, Counting, Sorting“.
Enjoy!
Gallery of the IOW Photo contest 2017
(for larger view plus image info click first picture of each row)